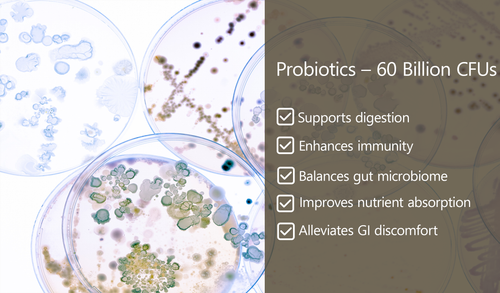

FAQs
- All
- PROBIOTIC & PREBIOTIC BLEND
- B'spoke Products FAQs
- B'spoke FAQs
PROBIOTIC & PREBIOTIC BLEND
Q1. Why 11 strains?
Multistrain probiotics offer broader gut, immune, and digestion benefits.
Q2. Why 60 billion CFU?
High potency ensures therapeutic effectiveness even after stomach acid exposure.
Q3. Why enteric-coated softgels?
So probiotics survive the stomach and reach the intestine alive.
Q4. Does this reduce bloating?
Yes — supports better digestion and reduces gas.
Q5. Does it help with constipation?
Yes — prebiotics improve stool bulk and gut motility.
Q6. Does it support immunity?
80% of immunity starts in the gut — probiotics modulate immune cells.
Q7. Can this help IBS?
Many IBS symptoms improve with multi-strain probiotics.
Q8. Is this beneficial post-antibiotics?
Essential — restores gut flora.
Q9. Should it be taken with food?
Preferably after meals.
Q10. Will this help nutrient absorption?
Yes — improves vitamin + mineral uptake.
B'spoke Products FAQs
Q1. Are B’spoke products clinically researched?
Yes — formulations are based on ingredients supported by randomized controlled trials (RCTs).
Q2. Are these products FDA-registered?
Manufacturing occurs in FDA-registered facilities.
Q3. Are the products lab-tested?
Every batch undergoes stringent third-party purity, potency, and contamination testing.
Q4. Are ingredients sourced globally?
Yes — only premium, globally certified suppliers are used.
Q5. Are the products WHO-GMP certified?
Manufacturing follows WHO-GMP standards.
Q6. Are the products safe for long-term use?
Yes — within recommended doses.
Q7. Are B’spoke products non-GMO?
Yes — clean, non-GMO ingredients are used.
Q8. Are the supplements halal?
Yes — Halal certification appears on the brochure.
Q9. Are the products free from heavy metals?
Yes — every batch undergoes contamination testing.
Q10. What makes B’spoke different from other brands?
Higher potency, RCT-backed formulations,
premium standardized extracts, and advanced delivery formats.
B'spoke FAQs
Q11. Can multiple products be combined?
Yes — products are designed to stack synergistically (e.g., Anti-Spike + Omega-3).
Q12. Do B’spoke products work for all ages?
Most are suitable for 18+, with some exceptions for teens based on product type.
Q13. How soon do results appear?
Varies by product — from 2 weeks for probiotics to 12 weeks for skin and metabolic changes.
Q14. Are there any side effects?
Minimal; the formulas use gentle, natural, clinically validated ingredients.
Q15. How does B’spoke ensure safety?
Through multi-step quality checks: ingredient sourcing → lab testing → GMP manufacturing → final product validation.